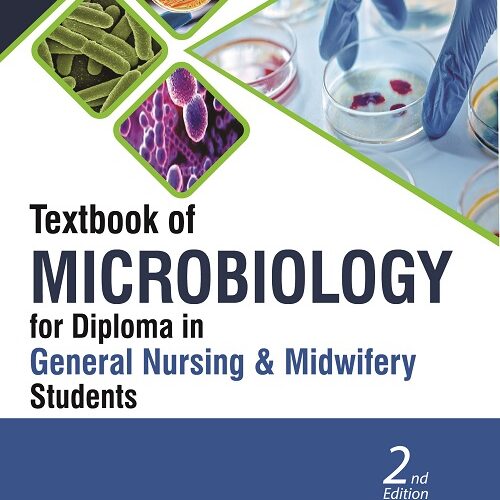
Textbook of Microbiology for Diploma in General Nursing and Midwifery Students

NURSING
“HEINE Classic+ Miller Pediatric Fiber Optic Laryngoscope Blade – F-000.22.122 (SIZE 2)” has been added to your cart. View cart
-
Sale!

-
Sale!

Nutrition for General Nursing and Midwifery by Ruma Singh
₹450.00Original price was: ₹450.00.₹382.50Current price is: ₹382.50. excl. gst -
Sale!

Nursing Education Principles and Concepts by R Sudha
₹795.00Original price was: ₹795.00.₹675.75Current price is: ₹675.75. excl. gst -
Sale!
Textbook of Microbiology for Diploma in General Nursing and Midwifery Students by Surinder Kumar
₹495.00Original price was: ₹495.00.₹420.75Current price is: ₹420.75. excl. gst -
Sale!

Golden Notes for Community Health Nursing-I by Parimal Patel
₹750.00Original price was: ₹750.00.₹637.50Current price is: ₹637.50. excl. gst -
Sale!

MEDICAL SURGICAL NURSING SYSTEMIC DISEASE AS PER INC SYLLABUS-2VOLS by by Cecy Correia
₹1,550.00Original price was: ₹1,550.00.₹1,286.50Current price is: ₹1,286.50. excl. gst -
Sale!

Textbook on First Aid and Emergency Nursing by I Clement
₹925.00Original price was: ₹925.00.₹786.25Current price is: ₹786.25. excl. gst -
Sale!

Essentials of Communication and Education Technology by Nisha Clement
₹895.00Original price was: ₹895.00.₹760.75Current price is: ₹760.75. excl. gst -
Sale!

Fundamentals of Nursing for General Nursing and Midwifery (Including First Aid) by SN Nanjunde Gowda
₹850.00Original price was: ₹850.00.₹722.50Current price is: ₹722.50. excl. gst -
Sale!

Essentials of Medical Surgical Nursing by Basavanthappa BT
₹1,195.00Original price was: ₹1,195.00.₹1,015.75Current price is: ₹1,015.75. excl. gst -
Sale!

English For Nursing by Sarumathi J
₹295.00Original price was: ₹295.00.₹250.75Current price is: ₹250.75. excl. gst -
Sale!

Textbook of Biochemistry for BSc Nursing: As Per Revised Inc Syllabus by Pankaja Naik
₹325.00Original price was: ₹325.00.₹276.25Current price is: ₹276.25. excl. gst -
Sale!

Food and Nutrition for Nurses (BSC Nursing) by Ruma Singh
₹675.00Original price was: ₹675.00.₹573.75Current price is: ₹573.75. excl. gst -
Sale!

Textbook of Pathology and Genetics for BSc Nursing Students by K Chaitra
₹1,395.00Original price was: ₹1,395.00.₹1,185.75Current price is: ₹1,185.75. excl. gst -
Sale!

Textbook of Applied Psychology by SUKHBIR KAUR
₹550.00Original price was: ₹550.00.₹467.50Current price is: ₹467.50. excl. gst -
Sale!

Textbook of Nursing Education By KP NEERAJA
₹850.00Original price was: ₹850.00.₹722.50Current price is: ₹722.50. excl. gst

HEINE Classic+ Miller Pediatric Fiber Optic Laryngoscope Blade - F-000.22.122 (SIZE 2)